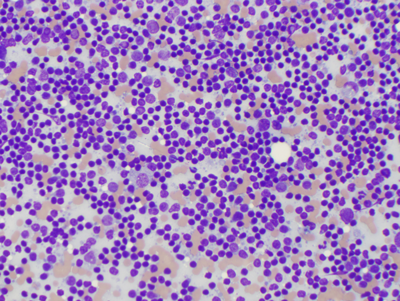

Gastrointestinal Signs in a Cat

A 9-year-old, 3.6-kg spayed female domestic shorthair cat was presented for evaluation of a 1-month history of poor appetite, weight loss, and intermittent vomiting.
HistoryThree weeks earlier the patient had been examined by another veterinarian, who prescribed an antibiotic (amoxicillin trihydrate/clavulanate potassium, 62.5 mg PO Q 12 H) and a gastroprotectant (famotidine, 2.5 mg PO Q 24 H). No improvement was reported, and clinical signs had gradually worsened since that time. The patient lives in a single-cat household, is current on all vaccinations, and does not spend time outdoors. The owner reported no history of exposure to toxins or ingestion of foreign material.
Physical Examination & Laboratory ResultsThe patient was bright and alert; approximately 5% dehydrated; and had moderate, diffuse muscle wasting. Oral mucous membranes were pink and tacky. Findings on thoracic auscultation were unremarkable. Abdominal palpation revealed thickened, ropey small intestinal loops and a midabdominal mass effect. The table lists the laboratory results.

ASK YOURSELF...• Describe morphologic characteristics of the cells.• Does the sample represent a neoplastic or reactive cell population?• What is your final diagnosis, and what is the origin of the abnormal cells?
Diagnostic ImagingThoracic radiography: Cardiac and pulmonary structures unremarkable
Abdominal ultrasonography: Multiple thickened segments of small intestine with loss of normal wall layering; multiple large, round, hypoechoic masses in midabdomen (presumed mesenteric lymph nodes)

(Figure 1)
CytologyDifferential diagnoses were neoplasia (lymphoma, intestinal adenocarcinoma, mast cell tumor), inflammatory bowel disease, and infectious enteritis. Multiple ultrasonography-guided fine-needle aspirates were collected from the abdominal masses (Figures 1 and 2).

(Figure 2)
DID YOU ANSWER...• The sample demonstrates a mostly homogenous population of discrete, round cells. Cells are large (2–3 ¥ the size of erythrocytes), with well-defined borders, and a high nuclear–cytoplasmic ratio. Cells have prominent round to ovoid nuclei—most with several nucleoli: and a moderate amount of basophilic cytoplasm. Most cells contain intensely staining magenta cytoplasmic granules. Moderate anisocytosis and anisokaryosis are present (Figures 1 and 2).• The monomorphic, homogenous cell population strongly supports a neoplastic process, especially in the absence of obvious inflammation.• The cellular characteristics support a diagnosis of high-grade lymphoblastic lymphoma of large granular cell type.
Diagnosis: Lymphoblastic Lymphoma (Large Granular Cell Type)
Lymphoma of large granular lymphocytes (LGLs) is an uncommon form of lymphoma. It has been described retrospectively in several small series of cats1,2 and less commonly in dogs.3

(Figure 3)
DiscussionClinically, LGL lymphoma is an aggressive, rapidly progressive disease. Patients typically have a clinical history of abnormal clinical signs lasting only a few weeks to months. The distribution of affected organ systems can mimic that of other forms of lymphoma; in cats, however, the gastrointestinal tract is the most commonly involved primary site because cells are most commonly derived from intraepithelial lymphocytes.4 In dogs, LGL neoplasia can present as acute leukemia or chronic lymphocytosis.3
Immunohistochemistry has determined that LGL lymphocytes are typically derived from CD8+ cytotoxic T cells or natural killer (NK) cells. CD8+ T cells will also stain positive for CD3 (a pan–T-cell marker). In contrast, NK cells do not demonstrate CD3 or CD8 and instead are characterized by expression of CD56.2
Cytologically, the primary morphologic feature that distinguishes LGL lymphoma from other forms of lymphoma (Figure 3) is the presence of obvious cytoplasmic granules. These granules probably represent preformed elements used in cell-mediated cytotoxicity (granzymes, perforin proteins), and appear as an intense azurophilic-magenta color on routine Wright–Giemsa stains.5
(Figure 4)
Small Cell LymphomaAn equally uncommon form of lymphoma is low-grade small-cell lymphoma (SCL). This disease is characterized by well-differentiated cells that resemble normal lymphocytes (Figures 4 and 5). As with LGL lymphoma, this disease is sporadically reported in dogs and is well-described in cats. It primarily affects the gastrointestinal tract in the latter species.6

(Figure 5)
In stark contrast to the high-grade lymphomas, SCL tends to be an indolent, slowly progressive disease. Clinical signs can develop over several months, and cats are often treated empirically with various medical regimens before tissue sampling is pursued. Cytologically, samples consist of a monomorphic population of small, differentiated lymphocytes. Cells are similar in size to erythrocytes and neutrophils, have intensely basophilic nuclei, and have scant amounts of basophilic cytoplasm. It can mimic inflammatory bowel disease and can therefore be difficult to diagnose on the basis of cytology alone. Instead, tissue biopsy (endoscopic, or preferably surgical full-thickness) is the preferred diagnostic approach because depth of tissue invasion is a key feature for distinguishing SCL from inflammatory bowel disease.